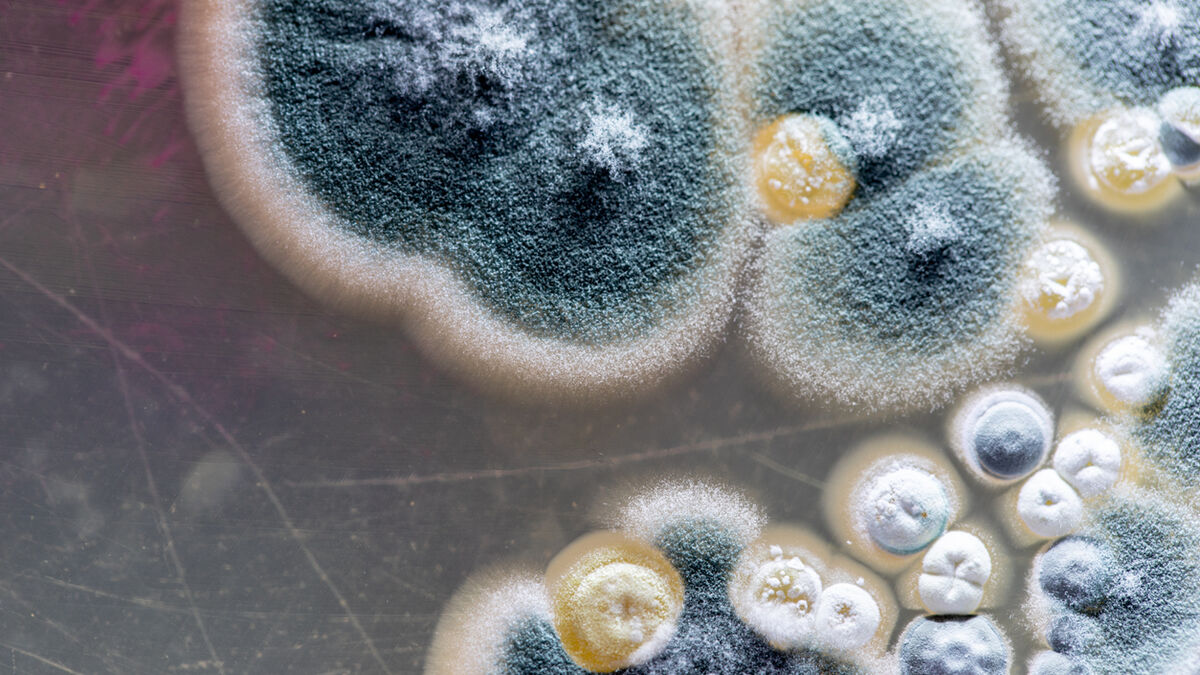
TikToker usa moho para maquillarse y se viraliza ¿Puso en peligro su vida?

TikTok ha permitido que miles de cibernautas se hagan virales, ya sea por algún talento o por imitar divertidos, excéntricos y hasta peligrosos retos. Tal es el caso de una joven mujer que ganó popularidad en dicha plataforma por presumir que utilizaba el moho para maquillarse.
En la grabación podemos observar un pincel intentando agarrar un poco del moho que ha crecido sobre una mandarina. Más adelante, vemos a la mujer pintarse el párpado sin problema alguno para después presumir ante la cámara el fabuloso smokey eyes en tono verde que había conseguido gracias a estos organismos microscópicos.
Aunque algunos señalaron que la joven no se había maquillado con la misma brocha, que el video estaba editado y que se trataba de una simple broma, los demás cibernautas señalaron lo peligroso que es que este video esté circulando en Internet debido a que otras personas no dudarán en imitarlo sin tener en cuenta los peligrosos efectos de estas bacterias.
Por tal motivo, la bióloga Angie Calderón compartió esta grabación en sus redes sociales y añadió un mensaje para todos los cibernautas, en el cual advierte de los peligros de replicar este reto viral: “Amigos, por favor no hagan esto en casa, no jueguen así con su salud, es algo peligroso”.
Bióloga advierte a comunidad de TikTok
Asimismo, ella explicó que las esporas de este hongo pueden llegar a ser muy dañinas para la salud, ya que provocan infecciones severas. De igual modo, recalcó que la situación puede llegar a ser más perjudicial para el ser humano si se aplica en zonas sensibles como los ojos.
De acuerdo a información que circula en Internet, misma que las noticias trae para ti, inhalar, tocar o consumir moho puede causar reacciones alérgicas, infecciones micóticas e irritaciones en los ojos, la piel, la nariz, la garganta y los pulmones. Asimismo, un dato curioso acerca de estos hongos es que pueden llegar a “pensar” sin tener un cerebro.

Fotografías: Redes Sociales
Síguenos en Facebook y entérate de las noticias trend de la semana


No hay comentarios.:
Publicar un comentario